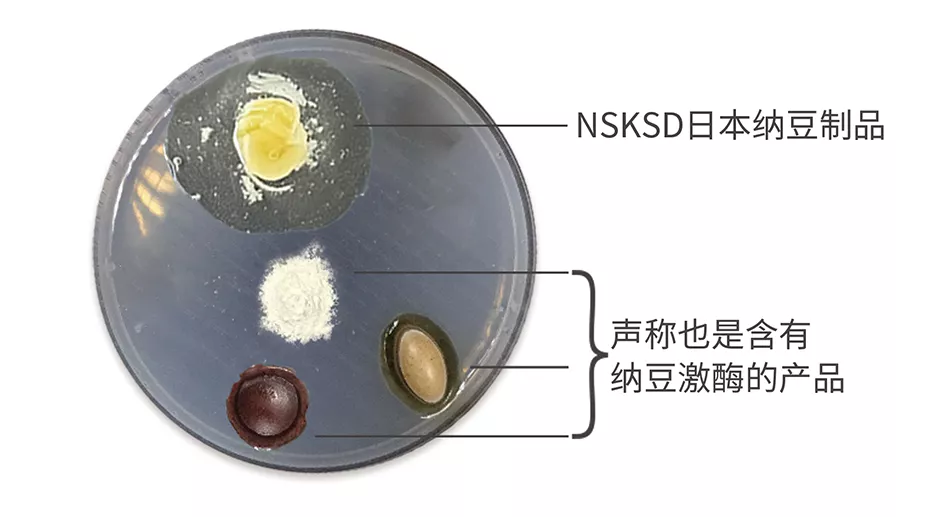
溶栓实验辨真伪

体外溶栓实验是辨别纳豆激酶真伪的一种简便、直观、科学的方法。当年须见洋行博士就是采用这种方法第一个发现纳豆激酶溶栓功效的。其实验内容如下:
37℃常温下,在培养皿中一块人工血栓上分别滴入尿激酶、血纤维蛋白溶酶、纳豆激酶。12小时后的溶栓效果(如下图)表明:纳豆激酶显示了更高的溶解度。
日本生物科学研究所的纳豆激酶NSK-SD引进到中国以来,为了验证其溶栓效果,并与中国市场的其他同类产品相比较,一直在进行溶解人工血栓的比较实验。实验的基本步骤如下:
首先,制作人工血栓。将纤维蛋白原倒入培养皿,用水均匀化开,然后滴入凝血酶,轻轻晃动器皿,使二者结合,数分钟后即可形成白色固体状人工血栓。第二,将日本生物科学研究所NSK-SD的产品内容物与对比试验的其他产品内容物,分别倒入制作好的人工血栓中。第三,把已经放入样品的人工血栓培养皿放置于热水杯上,使其溶栓环境近似于人体37℃的温度。然后,观察实验变化。对比实验图示如下:
5分钟后放置日本生物科学研究所纳豆激酶NSK-SD产品的人工血栓开始溶解松动;其他两款产品无溶解迹象。60分钟后,NSK-SD产品周围一圈大于2cm的血栓溶解,其他两款产品无溶解迹象。120分钟后,这种差距更加明显。
实验表明日本生物科学研究所纳豆激酶NSK-SD确实具有溶栓速度最快、溶栓能力最强的显著效果,而其他两款产品基本没有溶栓反应。
日本纳豆制品NSKSD进入中国市场十多年来,采用医学界公认的体外人工血栓即纤维蛋白平板实验法实验,确实具有显著的溶栓效果。而与之同步对比试验的数十款普通纳豆产品,无论是国产的还是其他进口的国外产品,都还没有发现这样的显著效果。
正文完